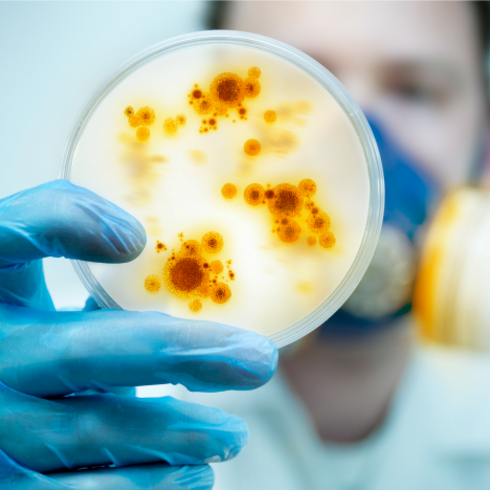

Yeshiva University










Skip past mobile menu to footer
Latest News
Featured News

Inductees Are Legendary Basketball, Fencing and Wrestling Coaches, All-Time Leading Scorers The legendary basketball coach Bernard “Red” Sarachek, fencing coach Arthur Tauber and wrestling coach Henry Wittenberg, along with the all-time leading women’s and men’s basketball scorers, are among the ...

Making the case for a Jewish Alexander Hamilton at Straus Center's inaugural "Early America and the Jews" program.

Students Express Appreciation to New York City Police Officers and Firefighters at #ShareYourThanks Event With Thanksgiving around the corner, Yeshiva University students reached out to local police officers and firefighters to express heartfelt appreciation for the role they play in keeping New ...
December 4 Student Medical Ethics Society Conference Will Explore History and Threats of Infectious Diseases Yeshiva University’s Student Medical Ethics Society (MES) will partner with YU’s Center for the Jewish Future (CJF) to explore the history, challenges and impact of infectious diseases at…

Sy Syms Student’s Team Wins Case Competition at Beta Gamma Sigma Global Leadership Summit Sy Syms School of Business senior Matan Horenstein was a member of the student team that won the case competition at the 2016 Beta Gamma Sigma (BGS) Global Leadership Summit in Dallas, Texas. The summit is a…

Board of Trustees Announces Appointment of Rabbi Berman as Yeshiva University's Fifth President The Board of Trustees has elected Rabbi Dr. Ari Berman '87YUHS, '91YC, ’94BR, ’95R as the fifth president of Yeshiva University. He will officially begin his tenure in July 2017. “Rabbi Berman is a ...

Students in Two-Year Program Will Experience Stellar Business Education, Spiritual Growth and Vibrant Campus Life Yeshiva University’s Mordecai D. and Monique C. Katz School of Graduate and Professional Studies has announced the launch of a new associate degree program that will expand…

Talmud Professor and Holocaust Survivor Rabbi Dr. Meir Fulda Shares Stories of Kindness and Respect During Dark Days On Wednesday, November 9, close to 100 students, faculty and members of the community filled the Rubin Shul on Yeshiva University’s Wilf Campus to hear from Rabbi Dr. Manfred Fulda…

Former New York State Assemblyman Phillip Goldfeder Aims to Strengthen Relationships Between YU and Government This month, former New York State Assemblyman Phillip Goldfeder joined Yeshiva University as assistant vice president for government relations. In his new role, Goldfeder is working to ...

Reception Honors Yeshiva University Employees Celebrating Milestone Anniversaries On Thursday, November 3, President Richard M. Joel and the Human Resources Department hosted a program and reception honoring YU employees on the Manhattan campuses who celebrated milestone anniversaries during 2016…
